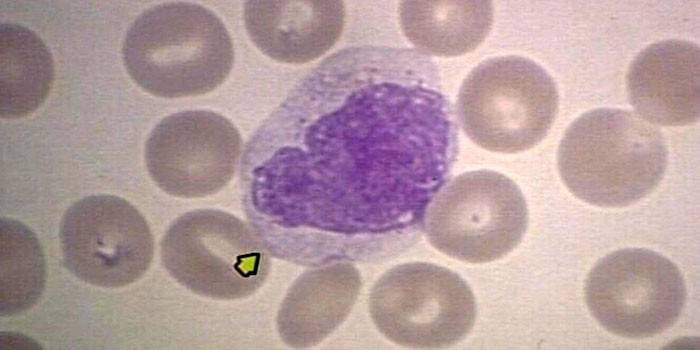

Monositler - bu nedir ve kanda ne sorumludurlar?
Kanın bileşimi incelendiğinde, bu biyolojik sıvının, benzersiz işlevlerini yerine getiren bir dizi hücreden oluştuğu anlaşılmaktadır. Böylece kandaki monositler, aktif fagositler, mikropları, virüsleri ve bakterileri yok eder; ancak vücuttaki etkilerinin spektrumu burada bitmiyor. Lökosit hücrelerinin konsantrasyonu düşürüldüğünde veya arttırıldığında, teşhisten sonra derhal konservatif yöntemlerle tedavi edilmesi gereken patolojik bir süreç vardır.
Kandaki monositler nelerden sorumludur?
Monositler, periferal kanda dolaşan aktif fagosit grubunun bir parçasıdır. Kemik iliğinde, hepatik sinüslerde, lenf bezlerinde, alveoler duvarlarda ve dalakta büyük miktarlarda bulunurlar. Tüm lökositlerin kan lekesinde, monositler en büyük, granül formundadır. Çekirdek hücrenin merkezinde bulunur, soluk mavi bir rengin sitoplazması azurofilik granüller içerir.
Promonositlere dönüşme aşaması da dahil olmak üzere monoblastlardan olgunlaşmamış monositlere hücre gelişim sürecine resmen “hematopoiesis” denir. Lökosit serisinin hücreleri, periferik kanda 3 günden daha uzun süre yaşamaz, daha sonra komşu dokulara ihraç edilir ve olgunlaşma aşaması tamamlanır, ardından olgunlaşmış “makrofajlar” oluşur. Bunların ana görevi vücudu virüslerden, bakterilerden, alerjenlerden, mikroplardan korumak ve patolojinin odaklarını azaltmaktır. Yetişkin makrofajların ana işlevleri aşağıda sunulmuştur:
- Makrofajların yüzeyinde bulunan insular reseptörler yabancı bir antijenin fragmanlarını T-lenfositlere daha fazla vermeleri ile bağlayabilirler.
- T lenfositler, sitokinler üreterek yabancı maddeleri yok etmek için makrofajları uyarır.
- Monositler, ekstravasasyon yapabilir, yani potansiyel patojenik patojenlerle etkileşime geçmek için kan damarlarının sınırlarının ötesine göç edebilir.
- Makrofajlar, demirin vücut tarafından emilimini önemli ölçüde artıran transferrin ihracat sentezi sağlar.
- Monositler, fagositoz ve endositoz (yabancı maddelerin emilimi) sağlarken, antijen ile temastan sonra ölmezler.
Monositler, yabancı istila sırasında lokal bağışıklık sağlayabilen koruyucu hücrelerdir. Ek olarak, makrofajlar, birkaç ardışık aşamayı içeren fagositoza karşı kararlı bir yetenek sergiler: kemotaksis (fagosit hücrelerinin antijenlere karşı hareketi), enflamatuar bölgeye nüfuz etme, kötü niyetli bir hücrenin yakalanması (zaten böyle bir prosesi, zaten kesilmiş olan ürünlerin tüketilmesiyle daha önce tüketilmiş olan endositoz veya pinositoz olarak adlandırılır) .

Monositlere kan bağışı
İltihaplanma şüphesi veya başka bir patolojik süreç varsa, doktor laboratuvarda yapılan bir klinik kan testi için gönderir. Bir lökosit formülüne olan ihtiyacı hemen vurgulamak gerekir, aksi takdirde laboratuvar asistanı yalnızca toplam lökosit sayısını hesaplar. Bu durumda ikinci bir laboratuvar testi yapmanız gerekecektir. Monositler, virüslerin ve bakterilerin artan aktivitesini baskılayan lökosit formülünün bir bileşenidir, vücudun bağışıklık tepkisinin değerlendirilmesine yardımcı olur.
Kan parmaktan alınır, sabahları ve her zaman aç karnına bağışlanması gerekir. Önceki gece, aşırı yağlı yiyeceklerin, kötü alışkanlıkların ve artan gerginliğin ortadan kaldırılmaması tavsiye edilir. Özellikle seçici olarak ilaç almak, örneğin, glukokortikosteroidler (hormonlar), antibakteriyel ilaçlar yanlış sonuç verir.
Monositlerin normları
Bir yetişkinde monositler yükselirse, bulaşıcı sürecin seyri hakkında konuşuruz. Gerekli gösterge patolojik olarak küçümsendiğinde, demir eksikliği anemisi gelişir. Mon'un bir kan testinde doğru ve zamanında tanınması için, kadınların, erkeklerin ve çocukların belli farklılıkları olan norm göstergelerini bilmeniz gerekir. Aşağıda tüm hasta kategorileri için geçerli monosit değerleri olan bir tablo yer almaktadır:
|
Yaş, cinsiyet |
Asgari% |
en çok% |
|
Yeni doğanlar |
3 |
12 |
|
1 yaşın altındaki çocuklar |
4 |
10 |
|
1 - 2 yaş arası çocuklar |
3 |
10 |
|
16 yaşın altındaki çocuklar |
3 |
9 |
|
16 yaşından büyük hastalar (kadınlar, erkekler) |
3 |
11 |
Ayrıca, kadın vücudunda, belirtilen aralığın yaşam boyunca önemli ölçüde değiştiğini açıklığa kavuşturmak önemlidir. Bu, doğum veya sezaryen ile bazı iç hastalıkları olan stresli durumlara daha fazla eğilim ile açıklanmaktadır. Erkeklerde, monositlerin normları büyük tutarlılık ile karakterize edilir. Çocukluk çağında, yenidoğanın doğumundan sonraki ilk haftalarda yeni yaşam koşullarına uyum sürecini unutmamak önemlidir.
Kandaki monositler yükselir
Monosit sayısı patolojik olarak fazla tahmin ediliyorsa, monositoz oluşur. Klinik tabloyu netleştirmek için analiz için kanı yeniden bağışlamak, ayrıca kesin bir tanı koymak için bir dizi laboratuvar testinden geçmek gerekir. Monositoz iki şekilde ortaya çıkar - göreceli ya da mutlak ve ilk durumda tehlikeli bir patolojiden bahsetmiyoruz ve kanın hücresel bileşiminin restorasyonu ek ilaç olmadan mümkündür. Kan monositlerinin yükselmesinin en yaygın nedenleri şunlardır:
- influenza'nın son aşaması, soğuk algınlığı, SARS;
- boğmaca, kızamık, kızıl, suçiçeği ilk aşaması;
- ilerici hamilelik dönemi (herhangi bir trimester);
- ameliyattan sonra uzun bir rehabilitasyon dönemi;
- önceki ameliyat sonrası radyasyon tedavisinin sonuçları.
Mutlak monositoz daha tehlikelidir, karmaşık klinik vakalarda yaygındır, kapsamlı tanı gerektirir. Kan bileşimi kendini normalleştirmez, doktor kök nedenini belirler, birkaç farmakolojik grubun ilaçlarının yardımıyla onu ortadan kaldırır.Bu durumda, zaten akut aşamada bile hastalığın ölümcül sonuçlarına neden olabilecek ciddi patolojilerden bahsediyoruz.
Monositoz Nedenleri
Kanın morfolojik bileşimi, kırmızı kan hücrelerini, trombositleri, beyaz kan hücrelerini, lenfositleri, eozinofilleri, nötrofilleri ve düşük konsantrasyonlarda hücre zarlarının koruyucuları olarak monositleri içerir. Bu tür parçacıklar patojenik bir enfeksiyonla başarılı bir şekilde savaşabilir, yabancı maddeleri emebilir. Bu tür tehlikeli hastalıklarla biyolojik sıvıdaki konsantrasyonları hızla artıyor:
- otoimmün hastalıklar: sistemik lupus eritematozus, romatoid poliartrit;
- çeşitli etiyolojilerin septik lezyonları;
- masif helmint istilası, bruselloz;
- karmaşık mononükleoz, kabakulak;
- sifiliz, tüberküloz (spesifik bakteriyel enfeksiyonlar);
- kalp ve eklemlerin romatizmal lezyonları;
- septik endokardit;
- enterokolit, ülseratif kolit, enterit;
- mantar lezyonları (kandidiyazis);
- vücudun fosfor veya tetrakloroetan ile zehirlenmesi;
- tifo, zatürree, zatürree;
- akut lösemi, diğer malign tümörler;
- viral hepatit B, ileri evre karaciğerin diğer patolojileri;
- ilerleyici lenfogranülomatozis;
- trombositopenik purpura, sıtma.
Kadınlarda
Kadın vücudunda, kandaki monositlerin sayısı, erkeklerde olduğundan daha sık artmaktadır, özellikle de ilerleyen bir hamilelik söz konusu olduğunda, fetüsün doğması durumunda, sitokinlerin üretimi ve göçü artmaktadır. Anti-enflamatuar etkileri olan bu tür maddelerin varlığı, karmaşık bir bağışıklık sisteminin doğal halini hamileliğe uyarlama sürecinin önemli bir bileşeni olarak kabul edilir. Ek olarak, rahatsız edici bir hormonal arka plan olumsuz bir etkiye sahiptir. Ancak bu şartlar altında normal aralıktaki önemli sapmalar gözlenmez.
Monositler biraz fazla abartılıyorsa, endişelenmek için bir neden yoktur. Hamile bir vücut, kendi başına patojenik mikroorganizmaların saldırısıyla başa çıkabilir. Kandaki monositlerin konsantrasyonu patolojik olarak artarsa ve monositoz ilerlerse, bazıları gelişmekte olan fetüs için özellikle tehlikeli olan viral enfeksiyonlar için test yapmak gerekir.
Bir çocuk
Çocuğun vücudunda monositler artarsa, bir kan testini bir parmağınızdan tekrar almak ve klinik tabloyu netleştirmek için bir dizi laboratuvar testi yapmak gereksiz olmaz. Bir seçenek olarak, bu grip, ARVI veya soğuk algınlığı sonrası doku onarımı dönemidir. Ancak daha tehlikeli patolojileri dışlamayın. Bunların arasında:
- helmint istilası;
- tekrarlayan viral enfeksiyonlar;
- Hodgkin hastalığı;
- kanserli tümörlerin gelişimi;
- akut lösemi.
İkinci durumda, çocuğun ölümüne neden olabilecek ciddi bir kan hastalığından bahsediyoruz. Pozitif dinamikleri hızlandırmak için, doktorlar çeşitli kemo ve radyasyon tedavisi uygularlar, böylece küçük bir hastanın ömrünü uzatmaya çalışırlar. Bir sağlık sorununa zamanında cevap verildiğinde, bir çocukta akut lösemi tedavi edilebilir. Monositler patolojik olarak yükseldiğinde, kanın morfolojik bileşimindeki değişikliklere ek olarak, hasta, patolojik işlemin ilerleyişini göz ardı ederek hastalığın görünür semptomları tarafından rahatsız edilir.

Yükseltilmiş monositlerle ne yapmalı
İlk adım, monositozun bağımsız bir hastalık değil, sadece iç patolojinin bir belirtisi olduğunu açıklığa kavuşturmaktır. İlk eleme işlemi olmadan, kan bileşimi parametreleri normalleştirilemez. Örneğin, soğuk algınlığı veya grip tedavisi görürseniz, 2-3 hafta sonra monositler normale döner. Eğer kanserden bahsediyorsak, lökosit parametrelerindeki uzun süre değişiklikler, kabul edilebilir göstergeler ile uyuşmuyor.Spesifik terapi yok, tedavi semptomatiktir.
Aşağıda, kandaki monositler patolojik olarak yükselmişse, uzmanların genel önerileri bulunmaktadır:
- İlk adım, patolojik bir süreci belirlemek için tam bir inceleme yapmaktır.
- Sebep vücudun tükenmesiyse, doktor her zamanki günlük diyette bir değişiklik olan bir vitamin tedavisi kürü vermelidir.
- Tüm kötü alışkanlıklardan vazgeçmek, altta yatan hastalığın olağan ilaç tedavisini tekrar gözden geçirmek önemlidir.
- Hamilelik sırasında, doktorlar ilk trimesterde monositler yükselirse ilaçla aceleyi önermezler. Bunun bir kadının ilginç pozisyonuna bir çeşit “adaptasyon” olması mümkündür. 2 ila 3 hafta sonra ikinci bir kan testi yapılması önerilir.
- Klinik kan testi sadece yardımcı bir tanı yöntemidir, bu nedenle tam bir klinik muayeneden geçmeden kesin tanı hakkında konuşmamalısınız.
- Gösterge çok yüksekse, hastanın kan verirken çok gergin olması ya da laboratuar testinden önce bir şeyler yemesi mümkündür. Ek semptomların yokluğunda, çok fazla panik yapmayın.
- İlaçları seçerken, kendi kendine ilaç kullanamazsınız, çünkü klinik tablo yalnızca ağırlaştırılabilir.
Azalan Monosit Sayısı
Gösterge hafife alındığında, bu aynı zamanda vücut hastalığının karakteristik bir işaretidir. Monositlerde geçici bir düşüş genellikle duygusal şok, katı bir diyet ve yanlış bir yaşam tarzı ile ilişkilidir. Bir laboratuar kan testinin sonuçları kabul edilebilir bir şekilde uyuşmuyorsa, olası nedenler aşağıda sunulmuştur:
- demir eksikliği anemisi;
- nötrofil sayısında azalma ile akut enfeksiyon;
- uzun süreli glukokortikosteroid tedavisi;
- kıllı hücre lösemi;
- pansitopeni;
- radyasyon hastalığı;
- vücudun tamamen tükenmesi;
- şok durumu.
Patojenik faktörü belirlemek için bir uzmana danışmanız ve bir teşhis almanız gerekir. Katılan doktor, ana provoke edici faktöre göre bireysel beslenme düzeltmesi, kötü alışkanlıkların tamamen reddedilmesi, demir içeren ilaçların oral yoldan verilmesini ve ilaç tedavisini önerir. Onkolojik süreçlerin yokluğunda ilaç tedavisinin en etkili olduğu kabul edilir, ancak sağlık sorununa bütünleşik bir yaklaşım önemlidir.

